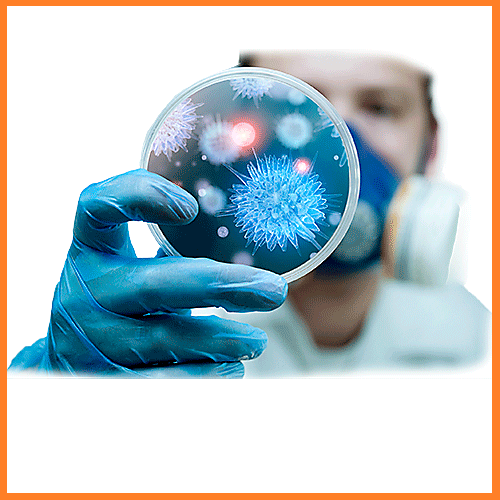

- Teacher: Prof. Dr. Shatha F Abdullah
- Teacher: Asst. Lec. Shaymaa Jwad Kadhem
- Teacher: Asst. Prof. Dr. Mustafa Nema
- Teacher: Lec. Dr. Hiba Sabah
- Teacher: Asst. Prof. Dr. Sarmad Zeiny

- Teacher: Asst. Prof. Dr. Asal Adnan
- Teacher: Prof. Dr. Assad Adnan
- Teacher: Lec. Dr. Ruba Ali
- Teacher: Lec. Dr. Aws Basheer

- Teacher: Lec. Dr. Nada Dheyaa
- Teacher: Lec. Dr. Ashwaq Talib Joodi

- Teacher: Prof. Dr. Muhammed Maroof Alani
- Teacher: Lec. Dr. Basim Mohammad Ibrahim


